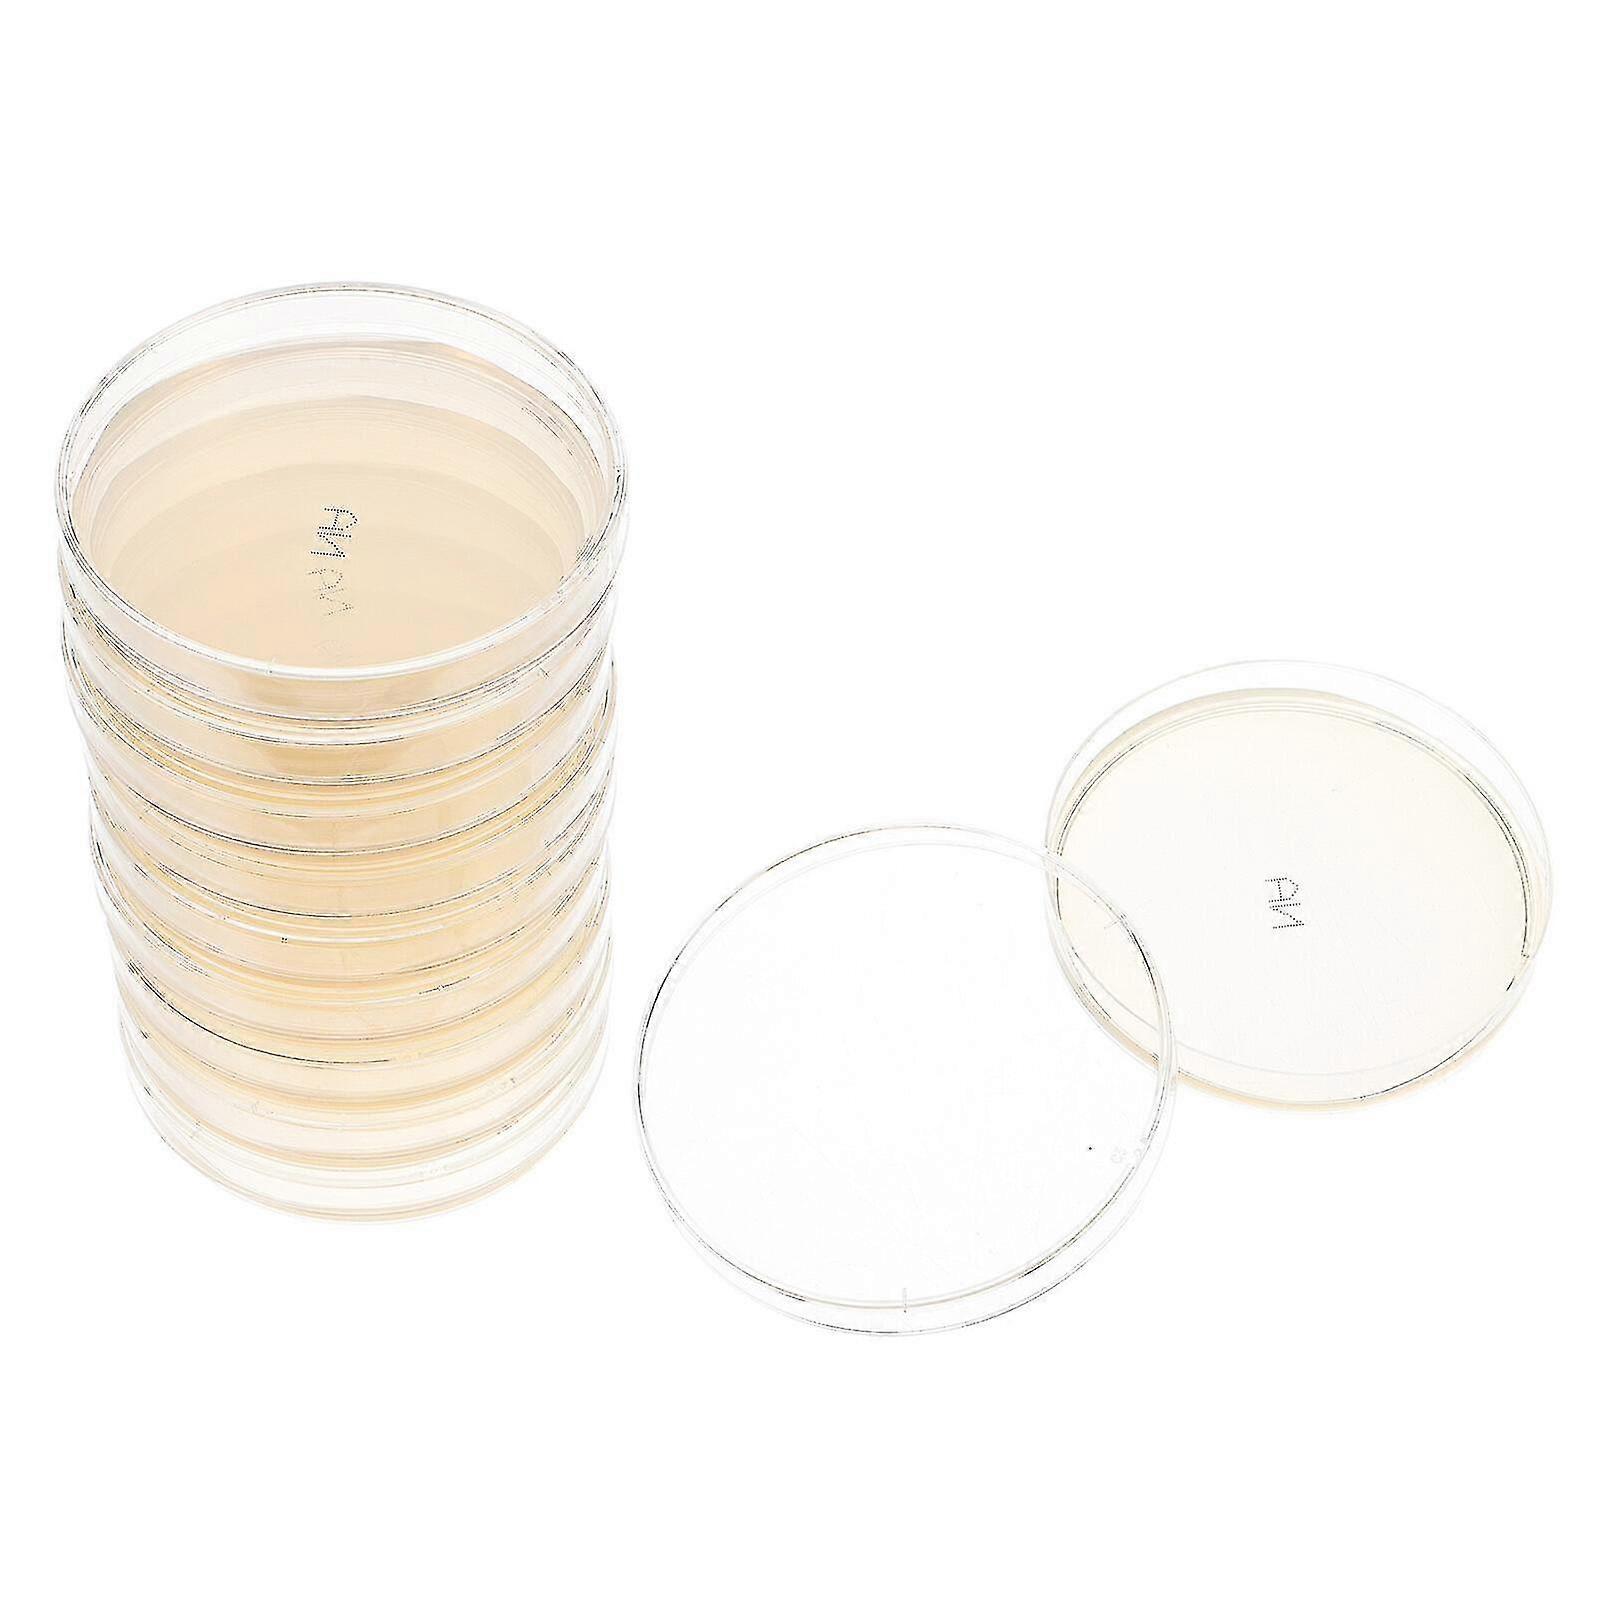

Agar Laboratuvarı Agar Plakaları ile 10 adet Petri Tabakları Genel Büyüme Ortamı
+ ₺736,99 Kargo
Agar Laboratuvarı Agar Plakaları ile 10 adet Petri Tabakları Genel Büyüme Ortamı
- Marka: Unbranded
Agar Laboratuvarı Agar Plakaları ile 10 adet Petri Tabakları Genel Büyüme Ortamı
- Marka: Unbranded
Önerilen Perakende Fiyatı: | |
Fiyat: | |
Kazancınız: | ₺1.100,00 (61%) |
Stokta var
Biz aşağıdaki ödeme yöntemlerini kabul ediyoruz
Tanım
- Marka: Unbranded
- Kategoriye Göre: Petri Kapları
- Fruugo Kimliği: 305094361-683467304
- EAN: 7013868859980
Ürün Güvenlik Bilgileri
Lütfen aşağıda özetlenen bu ürüne özel ürün güvenlik bilgilerine bakın.
Aşağıdaki bilgiler bu ürünü satan bağımsız üçüncü taraf perakendeci tarafından sağlanmaktadır.
Ürün Güvenlik Etiketleri

Teslimat ve İade
24 saat içinde kargoya verilir
-
STANDARD: ₺736,99 - Arasında teslimat Per 13 Kasım 2025–Sal 18 Kasım 2025
Kargo çıkış noktası Çin.
Sipariş ettiğiniz ürünlerin size bütün ve belirttiğiniz özelliklere göre teslim edilmesi için elimizden gelenin en iyisini yapıyoruz. Fakat, bütün gelmeyen veya siparişiniz ettiğinizden farklı çıkan bir ürünün elinize ulaşması ya da siparişinizden başka bir sebepten ötürü memnun kalmamanız durumunda, siparişi veya siparişe dahil ürünlerden herhangi birini iade edebilir ve ürünler için tam para iadesi alabilirsiniz. Tam iade politikasını görüntüle
Ürün Uyumluluk Ayrıntıları
Lütfen aşağıda özetlenen bu ürüne özel uyumluluk bilgilerine bakın.
Aşağıdaki bilgiler bu ürünü satan bağımsız üçüncü taraf perakendeci tarafından sağlanmaktadır.
Üretici:
Aşağıdaki bilgiler, Fruugo tarafında satılan bahsi geçen ürünün üreticisinin irtibat bilgilerini ortaya koymaktadır.
- LiPengpeng
- Shenzhenshi Yiyezi Keji Youxiangongsi
- No. 504, No. 13, Lane 11, Baolian New Village, Xixiang Street, Baoan District, Shenzhen
- Shenzhen
- CN
- 518100
- yiyezifruugo@outlook.com
- 18816765334
AB sınırları içerisindeki Sorumlu Kişi:
Aşağıdaki bilgiler AB sınırları içerisindeki Sorumlu Kişi’nin irtibat bilgilerini ortaya koymaktadır. Sorumlu kişi AB içerisinde konumlu olan atanmış iktisadi işlemcidir, Avrupa Birliği içerisinde satılan bahsi geçen ürün ile ilgili uygunluk yükümlülüklerinden sorumludur.
- Van Lavazza
- Y & H S.R.L.
- Via Gravina 21 MT matera,Trani,Puglia
- Trani
- Italy
- 75100
- itlyhsrl@gmail.com
- 0039 3917722149